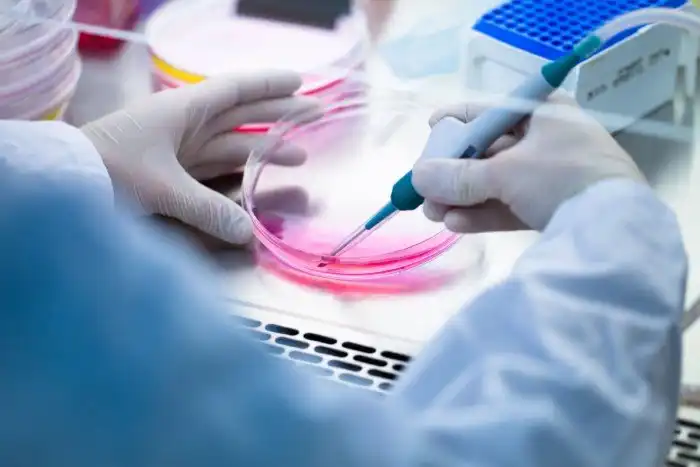

Удивительная реинкарнация тупиковой технологии клеточной терапии
В науке иногда происходят сюжетные повороты, которым могут позавидовать киносценаристы. Один такой пируэт, весьма затейливый, был продемонстрирован индуцированными плюрипотентными стволовыми клетками (ИПСК). Они должны были совершить революцию в медицине, но так и не смогли сделать это. Затем, однако, они заявили о себе с самой лучшей стороны.
Все клетки нашего организма призваны выполнять строго определенную роль. Нейроны, снабженные длинными аксонами, передают электрические сигналы. Эритроциты не имеют ядер, поэтому в них больше места для транспортировки кислорода. Но все они развиваются из скромных, непритязательных стволовых клеток, способных приобрести любое обличье. Раньше считалось, что происходящие с ними трансформации необратимы. Однако в 2006 году японский биолог Синъя Яманака отчитался об удивительном открытии.
Ученые, работавшие под его руководством, с помощью модифицированных вирусов внедряли 24 разных гена в сформировавшиеся клетки кожи. «Информационные агенты» перехватывали управление жизнедеятельностью и встраивались в ДНК хозяина. Начав расти, измененные клетки стали выглядеть и вести себя как стволовые, свойственные эмбрионам.
Синъя Яманака
В конечном итоге ученые оставили всего 4 из 24 генов – именно они требовались для трансформации взрослой клетки в стволовую. С их помощью был создан белок, управляющий экспрессией других генов. Он позволил превращать клетки кожи в нечто очень похожее на эмбриональные стволовые клетки. Результат этой трансформации, собственно, и называется сегодня ИПСК. Плюрипотентность в данном случае означает способность превращения практически в любой тип клеток.
ИПСК мгновенно стали восприниматься как удивительный прорыв в биологии стволовых клеток. Многие увидели в них невероятный медицинский потенциал. Это была настоящая мечта: неограниченный запас специфических клеток для восстановления органов и тканей, которые не будут отторгаться иммунной системой пациента, так как производятся его собственным организмом. Кроме того, ИПСК исключали любые вопросы этического характера, связанные с использованием стволовых клеток эмбрионов.
Первое клиническое испытание новой технологии было проведено в 2013 году. Ученые создали ИПСК из клеток кожи пациента с макулярной дегенерацией – это состояние, при котором человек теряет способность видеть вследствие повреждения сетчатки. Белок был введен реципиенту и улучшил его зрение. Однако эйфория от успеха оказалась недолгой.
После аналогичной операции на втором по счету пациенте ученые выявили мутации. По соображениям безопасности дальнейшие эксперименты были отменены. Этот провал, как кажется сегодня, был ожидаемым.
За 16 лет, прошедших с момента открытия ИПСК, продвинуться в этом направлении исследований так, по существу, и не удалось. Все из-за тех же генетических мутаций. По состоянию на 2021 год учеными было проведено всего 19 клинических испытаний с введением ИПСК, и лишь одно дошло до заключительной фазы.
Но, несмотря на то, что эти исследования зашли в тупик, ИПСК показали замечательный потенциал в смежных областях. Там, где те же мутации не являются особой проблемой, ведь ИПСК очень похожи на эмбриональные стволовые клетки.
Это позволило ученым создать биологические структуры, имитирующие стадию двухнедельного развития человеческого зародыша. Они образованы из трех слоев клеток разного типа, из которых впоследствии вырастают те или иные ткани, и могут быть использованы для исследования сложнейших процессов раннего развития, в том числе формирования органов и нервной системы.
Есть надежда, что изучение этих структур позволит понять, почему на этой стадии роста эмбриона возникает, в частности, такое неприятное врожденное заболевание, как порок сердца. До появления ИПСК подобные изыскания были запрещены по этическим соображениям, согласно которым зародыши старше двух недель нельзя было использовать в качестве материала для экспериментов.
С помощью ИПСК исследования могут проводиться буквально в чашках Петри. Возьмем, к примеру, болезнь Паркинсона. К моменту постановки этого диагноза большая часть выделяющих дофамин нейронов, находящихся в так называемой «черной субстанции» мозга, погибает.
Ученые создали ИПСК из клеток кожи и крови пациентов с болезнью Паркинсона, после чего вырастили достаточный запас нейронов этого вида. Теперь они могут спокойно изучать, почему погибают эти клетки, а также тестировать на них перспективные медикаменты. В будущем все это может привести к появлению технологий персонализированного лечения, когда ИПСК того или иного человека будут использоваться для назначения индивидуальных курсов борьбы с болезнью.
Индуцированные плюрипотентные стволовые клетки способны также решить вечную проблему дефицита донорских органов для пересадки. Здесь достаточно упомянуть эксперимент, когда клетки, взятые у мышей, были «встроены» в крысиные эмбрионы, у которых предварительно были отключены гены, отвечающие за формирование поджелудочной железы.
Чужеродные ИПСК тут же заполнили пустую нишу и превратились в искомый орган. Теоретически эта технология может использоваться для выращивания человеческих «запчастей» в организме, например, свиньи. Подобные эксперименты уже проводились. Существуют некоторые нюансы, с которыми нужно разобраться, но в целом все выглядит довольно перспективно.